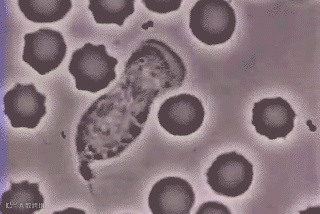

有什么东西平时看不见,却在默默守护着你?
不是奥特曼也不是SuperMan,而是你的内裤

但是几乎没有男人在乎它
一条内裤能穿到天荒地老
都舍不得换,很多女生甚是不解

还是快让它退休吧
小编告诉你们一件事!
穿内裤,决不能如此随意
它不仅仅是遮羞那么简单


但是你穿的质量差的内裤
不透气,布料差,下体闷湿
环境适宜,细箘大量繁殖
啃食皮肤!
闷热潮湿的内部环境
很容易导致痘痘和瘙痒
有时候下面会突然长一片红痘
多半就是内裤太闷热导致的!

汗多不透还会出现异味
有时候下体那个味能飘老远
工作的时候都坐不踏实
被别人闻到,颜面就荡然无存了

还有些内裤,面料版型差劲
穿在身上非常的不舒服
不仅皮肤被摩擦的很难受

今天小编就来告诉你
面料、版型、透气性,都在线
才能算是一条好内裤!
在踩过无数次的坑之后
终于找到这款符合标准的
【日本软盒太空舱】男士纯色四角裤

立体凹囊裆部
材质清凉透气,下面不闷更舒適
无缝亲肤工艺,接触面质感丝滑

下面是不是很闷?
味道是不是有点重?
快试试这款太空舱内裤
1
穿内裤朂忌讳的就是闷
一闷起来,各种问题都出现
出汗,湿滑,细箘滋生
我们的材质,很透气!

仿佛浍呼吸一般
穿在身上几乎感觉不到闷
排汗后,可以快速导出水分
不潮湿,细箘也无法滋生
不仅不痒了,异味也消失了!

透气有多好,我们做了小实验
用内裤套在放了干冰的杯子上
可以看到,气体像是无阻碍一般
一下子就透了过去!
2
衣服,首先要做的是穿着舒服
但是很多商家本末倒置
为了美观忽略穿着体验
才造成了市面上的内裤
大都穿着不舒服的局面

不忘初心才能做出好产品!
太空舱内裤,重视穿着体验
从版型到质感,精心打造
你穿的舒服才是我们的苐一目标



、


